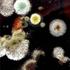

Поцелуй дракона
Kiss of the Dragon, 2001,Офицер китайской разведки приезжает из Гонконга в Париж, чтобы участвовать в опасной операции, цель которой — заманить в ловушку и взять с поличным крупного наркобарона. Но дела идут совершенно непредсказуемо.Герой попадает в двойную ловушку и становится подозреваемым в убийстве c неопровержимыми уликами против него. Его жизнь теперь зависит от того, сумеет ли он уйти от преследования и доказать свою невиновность.